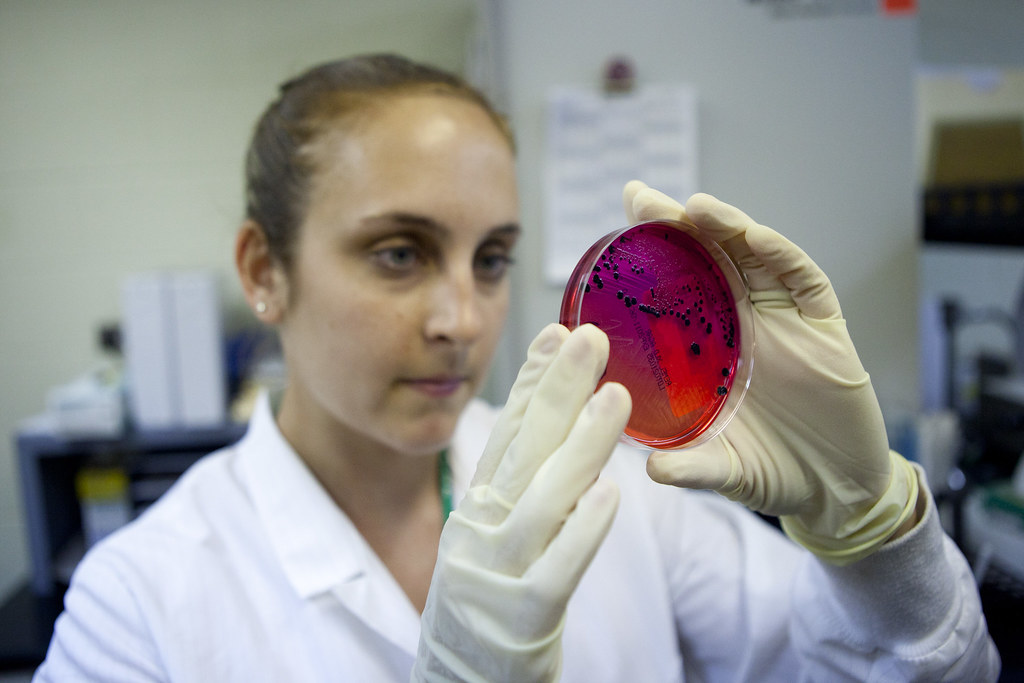
Google DeepMind Proposes New Framework for Intelligent AI Delegation to Secure the Emerging Agentic Web for Future Economies

The Avocado Pit (TL;DR)
- 🧠 IIIT-Delhi rolls out a new course on AI Fabrics, supported by industry partners.
- 👩🎓 Designed to blend artificial intelligence with textile innovation.
- 🔗 Aims to bridge the gap between academia and industry with real-world applications.
Why It Matters
So, what's the buzz about AI fabrics? Well, IIIT-Delhi is not just weaving theories but stitching together a course that combines artificial intelligence with textiles—two worlds that, until now, were about as connected as your Wi-Fi during a storm.
What This Means for You
For the curious minds out there, this means a chance to dive into a cutting-edge field where tech meets textiles. Whether you're a student or a tech enthusiast, this course offers a glimpse into the future where your clothes could someday be smarter than your phone. And for industry folks, it's a golden opportunity to latch onto new talent that thinks outside the fabric box.
The Source Code (Summary)
IIIT-Delhi has launched a pioneering course on Artificial Intelligence Fabrics, backed by some big names in the industry. This program is designed to explore the intersection of AI and textile technology, aiming to provide students with practical skills and insights into this innovative field. By collaborating with industry partners, the course promises to offer real-world applications and hands-on experience, bridging the gap between academia and the textile industry.
Fresh Take
In a world where everything is getting "smarter," why should our clothes be any different? This course might just be the thread that ties together AI and fashion, a realm where your T-shirt could monitor your health or even play your favorite playlist. While the idea might sound like something straight out of a sci-fi movie, it's actually happening. And it goes to show that innovation is not just about creating new things but about redefining the old in unexpected ways. Bravo, IIIT-Delhi, for teaching us that even fabrics can have a future in AI.
Read the full NDTV article → Click here